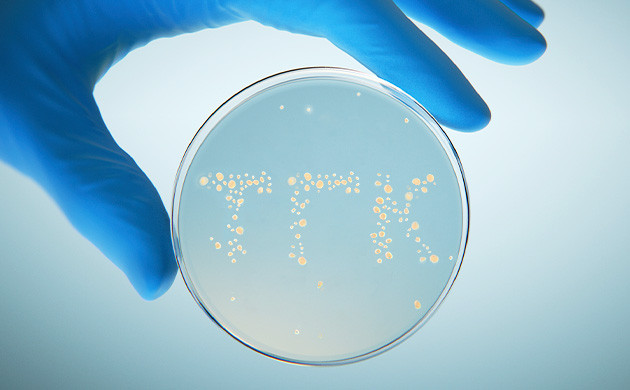
Синтезирование каннабиноидов

Еще каких-то 20-30 лет назад представление о выращивании каннабиса и качественной марихуане в целом было совершенно другим. В период строгого запрета и преследования со стороны властей фермерам по всему миру приходилось тратить уйму времени и сил на маскировку плантации. При этом на уход за растениями ресурсов уже оставалось не так много. Вот и приходилось довольствоваться малым.
С легализацией ситуация в конопляной индустрии сильно изменилась. Гроверам удалось выйти из тени, узаконить свою деятельность и полностью погрузиться в процесс культивации. Все это привело к более глубокому пониманию потребностей растений. Фермеры и крупные производители начали массово внедрять на своих плантациях новые технологии, оптимизируя процесс гровинга. Результат не заставил себя долго ждать. Инновационные технологии позволили в разы повысить производительность каннабиса, а вместе с тем и улучшить качество получаемого продукта.
Несмотря на то, что наша страна все еще находится очень далеко от светлого момента легализации, местные коноплеводы получили уникальную возможность воспользоваться опытом соседей и внедрить на своих партизанских посадках прогрессивные методы выращивания. В этой статье мы расскажем вам о последних тенденциях в области гровинга и канна-индустрии в целом. Погнали!
Новые технологии в гровинге Часть 2
Современные технологии гровинга
Технологии играют ключевое развитие в любой области жизни человека. И выращивание марихуаны не является исключением. Оптимизация производственных процессов значительно облегчает жизнь садоводу, помогает поддерживать оптимальные условия для развития растений и благоприятно сказывается на количестве и качестве собранного урожая. Ежегодно количество полностью автоматизированных, оснащенных по последнему слову техники ферм непрерывно растет. Уже не только крупные канна-предприятия, но и мелкие фермерские хозяйства, а также частные производители используют у себя в боксе или теплице современные Hi-Tech технологии.
Значительному развитию прогрессивных технологий в коноплеводстве способствовала легализация марихуаны. Данная сфера оказалась крайне прибыльной, так что многие инвесторы начали вкладывать в ее развитие немалые средства. Ежегодно все новые и новые страны пополняют список регионов с полным лигалайзом, и это ведет к незамедлительно растущему спросу на канна-продукцию. Параллельно проводятся новые исследования и разработки, так что в ближайшее время нас ждет ощутимый всплеск в области культивации каннабиса. А пока давайте разберем с вами наиболее значимые современные технологии культивации конопли.
Биосинтез каннабиноидов
Главными активными компонентами марихуаны являются каннабиноиды. Эти соединения взаимодействуют с нервной системой человека, обеспечивая как эйфорический, так и целебный медицинский эффект каннабиса. Преимущественно производители используют традиционные способы извлечения каннабиноидов из растительной массы. Вот только процесс это технически сложный и достаточно дорогой, что подтолкнуло ученых-биологов из Университета Саскачевана (Канада) к расшифровке механизмов синтеза каннабиноидов.
Им удалось не только полностью отследить весь путь естественного синтеза ТГК и КБД в трихомах конопли, но также разработать способы получения каннабиноидов при помощи дрожжей и микроорганизмов без участия растений. Такой подход с использованием генной инженерии позволит сократить посевы конопли и обеспечить поступление качественных и доступных продуктов для диспансеров и других точек продаж марихуаны.
Управление ростом
В последние годы среди прогрессивных гроверов набирает популярность техника Crop Steering или Управление ростом урожая. Она позволяет манипулировать развитием плантации за счет строго контроля показателей микроклимата. В качестве отклика на изменение окружающей среды каннабис меняет свой гормональный состав, что и приводит к ограничению роста, стимуляции бокового ветвления, более активному цветению и, как следствие, повышению производительности плантации.

Для успешной реализации технологии Generative Crop Steering потребуются немалые вложения. Методика требует строго контроля показателей температуры, влажности, освещения и циклов полива питательным раствором. Для этого используются высокоточные датчики и контроллеры, которые будут считывать, анализировать и вносить необходимые коррективы для создания оптимальной среды выращивания. Стоимость такого оборудования немаленькая, однако многие фермерские хозяйства внедряют подобные решения и совершенствуют технологию Управления ростом из-за ее высокой результативности.
Аэропоника
Наверное, каждый гровер наслышан о таком прогрессивном методе выращивания конопли, как гидропоника. Но сейчас мы хотим поговорить об одной из самых эффективных ее разновидностей – аэропонике. Ее принцип заключается в том, что корневая система растений находится буквально в воздухе, а питательный раствор подается к ней в виде водяного тумана, создающегося мелкодисперсными распылителями. В результате растениям не приходится тратить ресурсы и энергию на извлечение питания из почвы, а корни находятся в комфортной и максимально аэрированной среде.

Аэропоника обладает целым рядом преимуществ, среди которых можно выделить минимальный расход воды и удобрений, точный контроль рациона каннабиса, сокращение жизненного цикла растений и повышенная производительность с единицы площади выращивания. Кроме того, гроверу не нужно постоянно тратить деньги на покупку субстрата, а визуальная оценка состояния корневой системы позволяет своевременно реагировать на любые неблагоприятные изменения.
Аэропонику нельзя назвать сверхсовременной технологией. Она берет свое начало еще в середине прошлого века, а полномасштабное применение в гровинге получила в двухтысячные годы. При этом до сих пор многие коноплеводы практикуют использование аэропонных технологий для более рационального использования производственного пространства и повышения собственного профессионализма. Действительно, подобная техника культивации требует опыта и навыков ухода за растениями. Если вы также планируете попробовать свои силы в аэропонике, рекомендуем заглянуть на официальный форум Семяныча, где мы рассматриваем сразу три схемы изготовления аэропонных установок своими руками.
Вертикальная ферма
Многие растениеводы, которые не обладают огромными площадями для выращивания конопли, но при этом настроены на коммерческий урожай, прибегают к реализации вертикального гровинга. Эта технология позволяет по максимуму использовать каждый свободный сантиметр площади бокса или гроурума и повысить производительность без увеличения площади плантации.

Если при традиционном методе культивации в индоре растения стоят на полу или небольших подставках, то на вертикальных фермах горшки или поддоны с кустами располагают друг над другом, чтобы использовать все 100 % полезной площади пространства для гровинга. Лампы при этом могут находиться как над каждым ярусом стеллажей, так и сбоку от кустов. Это заставит растения развиваться не ввысь, а в сторону, формируя сплошные конопляные стены до самого потолка помещения.
Вертикальный гровинг активно используется мелкими производителями и фермерами, не обладающими большими площадями для выращивания. Этот метод уместен также для партизанского способа культивации конопли, ведь даже с крохотного неприметного помещения с его помощью удается собрать внушительный урожай шишек. Техника вертикального гровинга может быть реализована в любом помещении с высокими потолками. Она отлично сочетается с гидропонными технологиями и дает наилучший результат при использовании светодиодного освещения.
Искусственный интеллект и машинное обучение
За последние пару лет искусственный интеллект (далее ИИ) с громким шумом ворвался в жизнь человека. Уже сейчас при помощи нейросетей можно обработать фотографию, получить картинку или текст по заданным параметрам, найти ответы на многие интересующие вопросы и даже грамотно составить себе резюме, которое будет положительно выделяться среди анкет других кандидатов на должность. Однако это лишь самые простейшие задачи, с которыми может справиться ИИ.
Сельское хозяйство и коноплеводство, в частности, также имеет огромный потенциал для совместной работы с искусственным интеллектом. Для того чтобы растения могли активно расти и плодоносить, аграриям приходится тратить немало времени на контроль и корректировку условий выращивания. Вот только с большинством этих задач нейросеть справится даже лучше, чем самый опытный фермер.
ИИ способен подсказать гроверу более эффективный для его помещения способ культивации, модернизировать систему освещения или орошения плантации, предложить несколько вариантов по оптимизации процесса производства или даже с нуля разработать проект организации рабочего пространства. Не менее полезным будет ИИ и на этапе контроля параметров выращивания. Он может собирать самые разнообразные данные с различных датчиков, анализировать их и при необходимости вносить корректировки в работу оросительной или климатической техники.

Оснастив свою оранжерею камерами наблюдения с высоким разрешением, можно научить нейросеть выявлять признаки дефицита или профицита веществ, определять присутствие вредителей, анализировать общее состояние растений и на основе этих данных предлагать гроверу различные варианты решения проблем. Помимо этого, ИИ может прогнозировать дальнейшее развитие саженцев, опираясь на паспортные показатели сорта и исходное состояние растений с учетом всех особенностей помещения для выращивания. А еще он способен подсказать оптимальный момент для сбора урожая, отталкиваясь от фотографий трихом и предпочтений гровера касательно эффекта готового продукта.
Пользу от работы искусственного интеллекта ощутили и селекционеры марихуаны. Если загрузить в нейросеть генетическую структуру сорта, она может выявлять слабые места, определять достоинства и подсказывать наиболее эффективные пути гибридизации. По сути банальный анализ данных, только даже опытный бридер на это может потратить несколько месяцев, тогда как ИИ сделает все вычисления и прогнозы за считанные минуты.
Интернет вещей
Предшественником искусственного интеллекта был так называемый «интернет вещей» или на английском – IoT. По сути она представляла собой систему, которая могла получать и анализировать данные с различных источников, давая при этом обратный отклик на основе полученных данных. Для гроверов IoT представляла особый интерес, так как данная технология могла помогать собирать данные с различных датчиков в зоне выращивания, анализировать процессы роста и выдавать результат в понятном, доступном для восприятия виде.
«Интернет вещей» – отличный вариант для организации взаимосвязи между всеми элементами оборудования бокса, гроурума или теплицы. К ней могут быть подключены датчики влажности воздуха и почвы, система орошения, вентиляционная система, осветительные приборы, увлажнители, осушители, обогреватели, анализаторы почвы и многие другие приборы.
IoT способен значительно облегчить уход за плантацией и раскрыть весь потенциал используемого оборудования, особенно если оно подключено через системы автоматизации.
Автоматизация
Огромная доля работы по уходу за растениями является низкоквалифицированной. Она не требует каких-либо особых знаний и навыков, но при этом отнимает много времени и не дает сконцентрироваться на более продуктивных задачах. Для того чтобы избавить гровера от излишней суеты, современные технологии предлагают огромное количество автоматизированных гаджетов и приспособлений – от простейших систем автополива до сложных установок, способных самостоятельно анализировать состав почвы и проводить кормление в соответствии с потребностями растений в конкретный момент времени.

Автоматические системы для выращивания конопли способны значительно упростить жизнь гроверу, но на этом их преимущества не заканчиваются. Все мы как люди допускаем ошибки. Где-то перелил, где-то неправильно подготовил раствор, где-то забыл выключить освещение или не поднял лампы по мере роста кустов. Все это непременно приводит к стрессам и ухудшению здоровья растений. Роботы же работают по четкому алгоритму и не допускают ошибок. Они способны создать стабильную среду для стремительного и здорового роста конопли. В результате урожая получается больше, а затраты на оснащение окупаются в течение нескольких месяцев или лет в зависимости от объемов производства.
Единственным недостатком прогрессивных автоматических систем является высокая цена и необходимость в специфических навыках для их использования. В остальном они показали себя с лучшей стороны.
Светодиодное освещение
Бытовые LED лампы уже давно вытеснили с рынка устаревшие лампы накаливания и даже привычные для многих «экономки». Светодиодные технологии доказали свою эффективность не только в быту, но и в сельском хозяйстве. Специально разработанные для растений LED панели отличаются высокой энергоэффективностью и оптимальным спектральным составом света. В сравнении со следующими по популярности ДНаТ, они способны экономить значительное количество электроэнергии, при этом покрывая все потребности растений по части света.

Помимо прочего, светодиодные фито-светильники имеют минимальный нагрев во время эксплуатации. Это позволяет использовать их на близком расстоянии к растениям и проводить гров даже в самых тесных помещениях. Для них не требуется установка дополнительных систем охлаждения и отвода воздуха, так же как не нужна им и пускорегулирующая аппаратура, как в случае с теми же ДНаТ. Срок службы светодиодов обычно достигает 30 000 часов, а значит, и проработает такой светильник не один год.
Еще одним достоинством современного LED освещения для гроубоксов является вариативность относительно спектра свечения. Большинство панелей сейчас имеют не только диммер, корректирующий интенсивность светового потока, но и возможность регулировки спектра излучения в зависимости от стадии жизненного цикла растений.
Единственным фактором, который останавливает гроверов от повсеместного использования LED освещения, является их относительно высокая стоимость. Ценник на качественный светодиодный светильник сейчас стартует примерно от 10 000 рублей. Однако по мере развития технологий он определенно будет снижаться. А если учесть экономию на счетах за электричество, сомнений в необходимости такой покупки и вовсе не остается.
Технологии электронной коммерции
В наше время уже сложно кого-то удивить покупкой или продажей товаров посредством Интернет-ресурсов. Развитие технологий и времена ковида подтолкнуло многие торговые сети расширить свою сферу деятельности и перейти в онлайн-торговлю. Не оставила за бортом эта тенденция и канна-производителей. Конечно, в нашей стране сложно себе представить беспрепятственную работу магазинчика по продаже рекреационной марихуаны или даже медицинских концентратов, а вот в прогрессивных странах с полной или частичной легализацией, технологии электронной коммерции уже давно пополнились тематическими канна-площадками.
Через всемирную сеть очень просто найти покупателей, даже если магазин имеет весьма специфическую специализацию. При этом для того, чтобы начать вести торговлю через интернет, достаточно создать простенький сайт. Технологии электронной коммерции сокращают издержки, позволяя как производителям, так и потребителям работать без посредников. Система уже давно отлажена, отработаны различные варианты доставки и оплаты заказов, а все что остается продавцу – это подготавливать товар к отправке и передавать в почтовую службу. Просто, быстро и эффективно.
Неприхотливые сорта конопли

- Фотопериодные
- 28 %
- Ментальная эйфория, переходящая в релакс
- Индор: 700 г/м² Аутдор: 900 г/куст
Сорт конопли Peanut Butter OGKB пополнил ассортимент испанского сидбанка Original Sensible Seeds в качестве передового индика-доминантного гибрида. Селекционеры разработали его на основе невероятно популярного Do-Si-Dos, скрещенного с любимцем гурманов Cherry Pie Kush. В результате у них получилось первоклассное растение, которое может похвастаться длинным списком достоинств. Он отлично подойдет для гроверов любого уровня мастерства и направленности. Коммерческие производители непременно оценят высокую производительность и обильную смолистость соцветий, позволяющую изготавливать качественные экстракты и концентраты. Начинающие садоводы выберут его за неприхотливость и выносливость, благодаря которым выращивание не доставляет хлопот. Гурманы останутся довольны ярким терпеновым профилем, состоящим из приятного орехового аромата и сладкого фруктового вкуса. Что касается простых коноплеводов, то они придут в восторг от приличного уровня ТГК в 28%. Оно обеспечивает мощное комбинированное воздействие. Начинается все с безудержной эйфории, а затем постепенно сменяется тотальным релаксом.

- Фотопериодные
- 26 %
- Мощный церебральный high
- Аутдор: 1200 г/куст
Сорт конопли Moby Delicious является гордостью бридеров испанского сидбанка Delicious Seeds, которая представляет собой стабильное и выносливое растение с преобладанием генов Сативы. Его под силу вырастить даже новичку, а все благодаря надежной генетике, состоящей из знаменитого гибрида Moby Dick и не менее известного Royal Moby. Долгая и кропотливая работа позволила не только улучшить уже имеющиеся характеристики, но и пополнить их новыми. Семена сорта отлично подойдут для выращивания в закрытом грунте под искусственным светом, в гидропонной системе и на свежем воздухе под открытым небом. Они быстро превратятся в зрелые кусты с крепким центральным стеблем, сильным иммунитетом к болезням, высоким уровнем стрессоустойчивости и большим количеством плотных шишек, обильно налитых липкой смолой. После сушки и пролечки они превратятся в первоклассный готовый продукт, обладающий ярким ароматом цитрусовых фруктов и таким же вкусом, оставляющим после себя едва уловимое землистое послевкусие. Воздействие сопровождается эйфорическим хаем, наполняющим тело жизненной энергией, а сознание – светлыми чувствами.

- Автоцветущие
- 25 %
- Идеально сбалансированный high-stone
- Индор: 450 - 600 г/м² Аутдор: 50 - 250 г/куст
Сорт конопли Ztrawberriez Auto – это феминизированный автоцветущий гибрид, в ДНК которого преобладают гены Сативы. Он может похвастаться крепким иммунитетом, богатым терпеновым профилем, высоким показателем ТГК в 25%, стабильным ростом, неприхотливым характером и коротким жизненным циклом. Его семена проходят путь от посадки до сбора урожая всего за 9-10 недель, постепенно превращаясь в стойкие и выносливые кусты, которые по ходу своего развития формируют длинные второстепенные ветви и очень толстые соцветия, растущие очень близко друг к другу. Также на стадии цветения они окрашиваются в пурпурный цвет, создавая вместе с белоснежными трихомами живописную картину. Итоговая урожайность зрелых растишек составит 450-600 грамм шишек с одного квадратного метра в закрытом грунте и 50-250 грамм с одного куста под открытым небом. Эффект воздействия готового продукта представляет собой идеально сбалансированный high-stone, поднимающий настроение, снимающий усталость и мотивирующий на новые свершения. Дополнением к нему идет приятный аромат дизельного топлива со сливочными тонами на пару с ягодным вкусом.

- Фотопериодные
- 24 %
- Баланс веселья и расслабления
- Индор: 500 г/м² Аутдор: 700 г/куст
Сорт конопли Monster Girl Scout Cookies является результатом слияния легендарного OG Kush и не менее известного Durban. Благодаря такой родословной индика-доминантный гибрид может похвастаться крепким иммунитетом, мощным воздействием, ярким терпеновым профилем, неприхотливым нравом и приличным показателем ТГК в 24%. На цветение у кустиков уходит около 9 недель, которых более чем хватает для того, чтобы сформировать немалое количество смолистых соцветий, покрытых слоем серебристых трихом, переливающихся на свету всеми цветами радуги. Семена будут чувствовать себя комфортно как на свежем воздухе, так и в искусственных условиях. После сушки и пролечки спелые шишки превратятся в качественный готовый продукт, пропитанный нежным ореховым ароматом и сладким фруктовым вкусом. Кроме этого, он также отличается веселящим эффектом, постепенно перетекающим в глубокий релакс. Прекрасное средство для снятия ментального и физического напряжения, а также борьбы со множеством других недугов.

- Фотопериодные
- 24 %
- Яркий эйфорический high
- Индор: 500 г/м² Аутдор: 250 - 400 г/куст
Сорт конопли Critical Amnesia – это стойкий феминизированный гибрид, созданный в результате слияния сразу нескольких культовых генетик. Селекционеры американского сидбанка AlphaFem Seeds потратили немало времени и сил на отбор родительских генетик, пока в конечном итоге не остановились на сочетании урожайного Amnesia, ароматного Skunk #1 и выносливого Afghani. Итоговый результат превзошел все ожидания, и растение быстро обрело популярность на канна-рынке. Из его семян вырастают крепкие кусты с коротким расстоянием между узлами, небольшими листьями, разветвленной корневой системой и плотными смолистыми соцветиями. Их максимальная высота достигает 200-300 сантиметров, поэтому любителям скрытного выращивания придется прибегнуть к различным тренировкам. Отцветает растишка за 8-10 недель, принося 250-400 грамм готового продукта с одного квадратного метра в индоре и 250-400 грамм с одного куста в аутдоре. Воздействие можно охарактеризовать как яркий эйфорический high, растекающийся по телу живительной энергией и позитивом.
*Вся представленная информация носит исключительно ознакомительный характер и не является руководством или призывом к действию.
**Напоминаем, что использование семян марихуаны в качестве посевного материала (выращивание конопли с целью получения растения) запрещено УК Российской Федерации. Подробнее с законом Вы можете ознакомиться здесь.










Все комментарии проходят модерацию. Правила для публикаций:
Общие вопросы, не относящиеся к статье, также будут удалены.